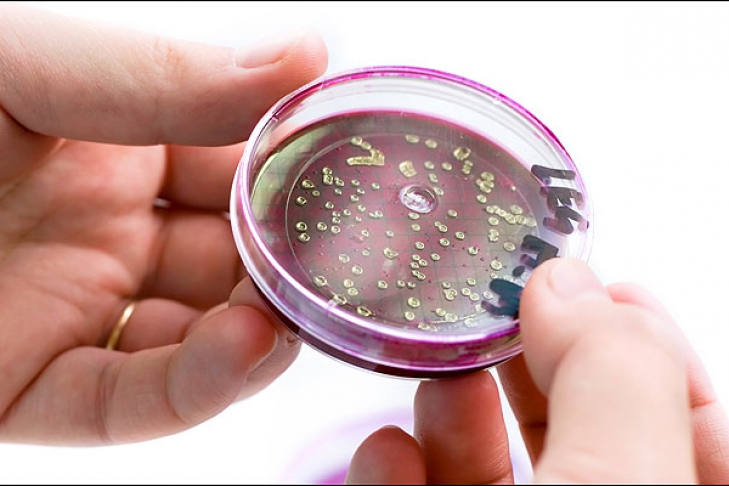

10:24 / 14.06.2011
Мир 
В Германии от E.coli погибли уже 36 человек
Всего же заболели более 3 тыс. 220 граждан
В Германии число умерших от кишечной инфекции, вызванной бактерией E.coli, возросло до 36 человек, сообщает радио «Свобода».
По данным берлинского Института Роберта Коха, всего заболели более 3 тыс. 220 человек.
В воскресенье, 12 июня, германский Федеральный институт оценки рисков для населения назвал эту вспышку инфекции самой масштабной из всех подобных, зарегистрированных до сих пор в мире.
Ранее сообщалось, что опасная бактерия «подобралась» к Украине.
В то же время в Мариуполе были выписаны 11 человек, заболевших холерой.





 Политика «Зеленський заявив, що Путін «обирає війну» і уникає миру»
Политика «Зеленський заявив, що Путін «обирає війну» і уникає миру»  Политика «Швеція дозволила передачу Україні суховантажу Caffa, підозрюваного в вивезенні зерна з окупованих територій»
Политика «Швеція дозволила передачу Україні суховантажу Caffa, підозрюваного в вивезенні зерна з окупованих територій»  Происшествия «На Хмельниччині було скоєно напад на військовослужбовця ТЦК»
Происшествия «На Хмельниччині було скоєно напад на військовослужбовця ТЦК»  Экономика «МАГАТЕ: Ключова лінія живлення ЗАЕС під загрозою після атаки на Запорізьку ТЕС»
Экономика «МАГАТЕ: Ключова лінія живлення ЗАЕС під загрозою після атаки на Запорізьку ТЕС»  Происшествия «Польські правоохоронці затримали «Заслуженого юриста України» за підозрою у пропозиції хабара»
Происшествия «Польські правоохоронці затримали «Заслуженого юриста України» за підозрою у пропозиції хабара»  Происшествия «Внаслідок російської агресії з 2022 року в Україні загинули 707 дітей, наймолодшому було всього два дні»
Происшествия «Внаслідок російської агресії з 2022 року в Україні загинули 707 дітей, наймолодшому було всього два дні»